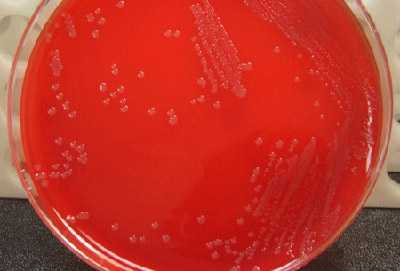
Figure 6 is a picture showing proper streaking and growth of N. meningitidis on a blood agar plate (BAP).
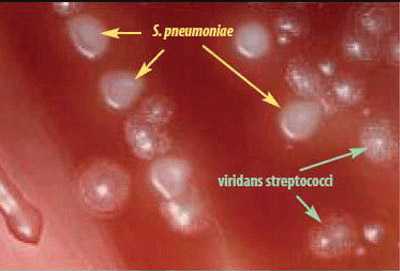
Figure 15 is a picture showing that S. pneumoniae colonies have a flattened and depressed center after 24-48 hours of growth on a blood agar plate (BAP), whereas the viridans streptococci retain a raised center.

Chapter 6: Primary Culture and Presumptive Identification of Neisseria meningitidis, Streptococcus pneumoniae, and Haemophilus influenzae
Printer friendly version [26 pages]
Microbiology laboratories commonly receive cerebrospinal fluid (CSF) or blood specimens from patients with meningitis, pneumonia, or unexplained febrile illness. Laboratories may also receive joint fluid, pleural fluid, or other sterile site specimens from these patients. Presumptive identification of N. meningitidis, S. pneumoniae, and H. influenzae can be made on the basis of a cytological examination of the CSF, specific colony morphology on blood and/or chocolate agar, staining properties on a Gram stain, or by detection of specific antigens in the CSF by a latex agglutination test or using a rapid diagnostic test (RDT). Methods for confirmatory identification of N. meningitidis, S. pneumoniae, and H. influenzae are presented in the next chapters of this laboratory manual (Chapters 7: Identification and Characterization of N. meningitidis, 8: Identification and Characterization of S. pneumoniae, and 9: Identification and Characterization of H. influenzae).
Personnel who are at risk of routine exposure to aerosolized N. meningitidis should strongly consider vaccination. Additional health and safety information can be found in Chapter 4: Biosafety. While laboratory-acquired infections with S. pneumoniae or H. influenzae are not as extensively reported, fatal infections with these bacteria can occur, and vaccination against these organisms may be recommended in some laboratories.
Because the primary purpose of this manual is to aid in the identification of N. meningitidis, S. pneumoniae, and H. influenzae from clinical specimens collected from suspected cases of bacterial meningitis, the methods described here will not allow for identification of other isolates that may be of clinical importance but are less likely encountered. Microbiologists should refer to clinical microbiology manuals, such as the American Society for Microbiology's Manual of Clinical Microbiology, for procedures to identify other bacteria.
-
Processing CSF specimens
A note about centrifugation: g (1 x gravity) represents relative centrifugal force (RCF), but the recommended centrifugation speed is often listed in protocols as revolutions per minute (RPM). RCF is dependent on the length of the radius of the rotor, thus the same RPM may not generate the same g force in another centrifuge. Therefore, RCF should be used to describe the centrifuge speed. If only RPM is given, RCF can be calculated using this formula:
RCF = 0.00001118 x r x RPM2
r = radius of rotor in centimetersOnce the CSF arrives in the microbiology laboratory, the volume of CSF available for analysis should be noted. If < 1 ml of CSF is available, it should not be centrifuged; instead, the CSF should be plated directly onto a blood agar plate (BAP) and onto a chocolate agar plate (CAP) and also used for the Gram stain. If > 1 ml of CSF is available (i.e., if the specimen volume is sufficient for centrifugation), it must be centrifuged at a force sufficient to sediment the bacteria. Typically, centrifugation at 1000 x g for 10-15 minutes is sufficient to sediment bacteria.
After the specimen has been centrifuged, the supernatant should be drawn off with a Pasteur pipette and reserved if antigen detection by latex agglutination is planned. The sediment should be vigorously mixed (e.g., in a closed tube using a vortex machine). Once it has been well-mixed, one or two drops of sediment should be used to prepare the Gram stain and one drop should be used to streak the primary culture media.
-
Cytological examination of the CSF
Laboratory examination of the CSF is usually the first step to confirm the presence of bacterial meningitis. Note that cytological examination should precede centrifugation and heating of the CSF. Typical CSF abnormalities associated with bacterial meningitis include the following:
- Turbidity
- Increased opening pressure (>180 mm water)
- Pleocytosis (usually of polymorphonuclear (PMN) leukocytes); WBC counts > 10 cells/mm3
- Decreased glucose concentration (<45 mg/dl)
- Increased protein concentration (>45 mg/dl)
Note: normal cytology of the CSF of an infant is 10-30 WBC/mm3 (50% PMNs).
-
Presumptive identification by Gram stain, latex agglutination, or rapid diagnostic test (RDT)
In combination with a clinical picture and CSF examination consistent with bacterial meningitis, a presumptive diagnosis of bacterial meningitis caused by N. meningitidis, S. pneumoniae, or H. influenzae can be made after performing a Gram stain of the CSF sediment or by detection of specific antigens in the CSF by a latex agglutination test or using RDTs. Positive results for any of these tests can rapidly provide evidence of infection, even if cultures fail to grow.
-
Performing a Gram stain
The Gram stain is an empirical method for differentiating bacterial species into two large groups based on the chemical and physical properties of their cell walls. Gram-positive bacteria retain the primary stain while gram-negative bacteria take the color of the counterstain. A Gram stain can also serve to assess the quality of a clinical specimen. The CSF should be properly centrifuged in order to obtain the sediment for the procedure. Proper smear preparation using the CSF sediment should produce a monolayer of organisms sufficiently dense for easy visualization but thin enough to reveal morphological characteristics. Clean, new glass slides should be used. Positive and negative quality control (QC) strains should be tested along with the unknown specimens. In addition to known reference strains for N. meningitidis, S. pneumoniae, and H. influenzae, other reference strains that may be used include Staphylococcus aureus for gram-positive cocci and Escherichia coli for gram-negative rods.
Gram stain procedure for CSF
- Centrifuge the CSF for 10-15 minutes at 1000 x g, if > 1 ml is available (see above).
- Divide a glass slide into two sections using a marker. Use one section for the unknown CSF and the other section for a known organism for QC.
- Prepare a smear by placing 1-2 drops of the well-mixed CSF sediment on the slide, allowing the drop(s) to form one large slightly turbid, uniform suspension.
- To prepare a smear using an isolate, add a small drop of sterile water or physiological saline to the slide and create a slightly turbid, uniform suspension of cells from an overnight culture.
- Let the suspension air dry. The suspension MUST be completely dry before proceeding.
- Fix the smear by the flooding the slide with 95% methanol for a minimum of 2 minutes (3). Rinse with distilled water. Shake off excess water.
- If methanol is not available, heat-fix the smears by quickly passing the slide through a flame three times. Do not over-heat the slide as over-heating will cause significant distortion or destruction of the cells.
- It is possible to use simple water (filet d'eau de robinet) if distilled water is not available for the entire Gram stain procedure.
- Flood the slide with crystal violet ammonium oxalate for 1 minute to stain. Rinse with distilled water. Shake off excess water.
- Avoid touching the slide with the tip of the reagent bottle or applying liquid directly onto the smear.
- Flood the slide with Gram's iodine for 1 minute. The iodine acts as a mordant as it binds the alkaline crystal violet dye to the cell wall. Rinse with distilled water. Shake off excess water.
- Decolorize with 95% ethanol until no more stain washes off (5-10 seconds may be enough). Rinse with distilled water. Shake off excess water.
- It is essential to view decolorization closely: gram-positive bacteria can be made to appear gram-negative by over-decolorization and gram-negative bacteria can be made to appear gram-positive by under decolorization.
- Counterstain with safranin for 30 seconds or with carbol-fuchsin for 10-15 seconds. Rinse with distilled water. Shake off excess water.
- Gently blot the slide using bibulous paper or a clean paper towel. Let air dry.
- When dry, examine the stained smear under a microscope with 100X oil immersion objective.
Reading the Gram stain results (under microscopic examination):
- Gram-positive organisms will appear dark violet or purple.
- Gram-negative organisms will appear red or pink (from the counterstain).

Figure 1. Gram stain of N. meningitidis in CSF with associated PMNs.
N. meningitidis may occur intracellularly or extracellularly in PMN leukocytes and will appear as gram-negative, coffee-bean shaped diplococci.
-
Performing latex agglutination testing
Several commercial kits are available for latex agglutination testing. General recommendations and instructions for the detection of soluble bacterial antigens (capsular polysaccharide) are provided below, but the manufacturer's instructions included in the kit should be followed precisely when using these tests. For best results, the supernatant of the centrifuged CSF specimen should be tested as soon as possible. If immediate testing is not possible, the CSF specimen can be refrigerated (between 2-8°C) for several hours, or frozen at -20°C for longer periods. It is imperative that the kits be kept refrigerated before use, but never frozen, especially in tropical climates as the kits deteriorate at high temperatures which may make the test results unreliable before the expiration date of the kit.
Latex agglutination procedure for CSF
Follow the manufacturer's instructions on the package insert for the specific latex kit being used. General instructions are listed below:
- Centrifuge the CSF for 10-15 minutes at 1000 x g and collect the supernatant.
- The sediment should be used for Gram stain and primary culture.
- Heat the CSF supernatant to be used for the test at 100°C for 3 minutes.
- Shake the latex reagents gently until homogenous.
- Place one drop of each latex reagent on a disposable card provided in the kit or a ringed glass slide.
- Add 30-50 µl of the supernatant of the CSF to each latex reagent.
- Rotate by hand for 2-10 minutes. If available, mechanical rotation at 100 rpm is recommended.
- Avoid cross-contamination when mixing and dispensing reagents.
- Examine the agglutination reactions under a bright light without magnification.
Reading the latex agglutination results
- Positive reaction: agglutination (or visible clumping) of the latex particles and slight clearing of the suspension occurs within 2-10 minutes (Figure 4).
- Negative reaction: the suspension remains homogenous and slightly milky in appearance.
- Centrifuge the CSF for 10-15 minutes at 1000 x g and collect the supernatant.
- Rapid diagnostic tests (RDTs)
-
RDT for meningococcal meningitis
RDTs have been developed for direct testing of CSF specimens without prior heat or centrifugation (2). The test is based on the principle of vertical flow immunochromatography in which gold particles and nitrocellulose membranes are coated with monoclonal antibodies to capture soluble serogroup-specific polysaccharide antigens in the CSF. The test consists of 2 duplex paper sticks (also called dipsticks), which together enable identification of four serogroups of N. meningitidis (A, C, W135, and Y). RDT1 tests for serogroups A and W135/Y and RDT2 tests for serogroups C and Y.
RDTs can be produced in large quantities, are relatively inexpensive, and remain stable for weeks in hot weather if protected from humidity; therefore, they are practical for immediate testing of specimens obtained during adverse conditions. Initial evaluation using RDTs on stored CSF from patients in Niger showed correct identification of the meningococcal serogroup 97% of the time (4). However, more recent studies under field conditions have shown similar specificity, but much lower sensitivity of 70% (6) and, in contrast, similar sensitivity but much lower specificity (5).
RDT procedure for CSF
Follow the manufacturer's instructions on the package insert. General instructions are listed below:
- RDTs should be stored at 4°C in a moisture-proof bag until use.
- Place the two dipsticks (RDT1 and RDT2) into two separate tubes (3 ml disposable plastic tubes are recommended) of 150-200 µl of CSF or a reference strain suspension in PBS, pH 7.2.
- Record the chromatographic result on each strip after 10-15 minutes at room temperature (25°C).
Reading the RDT results
- Appearance of red lines on the dipsticks will indicate whether one of the four meningococcal serogroups has been detected in the CSF (Figure 5).
- The upper line on the dipstick is the positive control and should always be present.
- If the CSF is positive for one of the serogroups, a lower red line will also be present. The position of that red line indicates the specific serogroup based on the RDT that was tested. See Figure 5 for result combinations for each serogroup.
- A negative result consists of a single upper pink control line only.
-
RDT for pneumococcal meningitis
RDT commercial kits are also available for S. pneumoniae detection by immunochromatography. The principle is the same as the one described above for N.meningitidis. Follow the manufacturer's instructions on the package insert.
-
-
-
- Primary Culture
-
Selection of primary culture media
The best medium for growth of S. pneumoniae is a blood agar plate (BAP), which is a trypticase soy agar (TSA) plate containing 5% sheep blood. Human blood is NOT an acceptable substitute for the blood in the agar because the antibodies contained in human blood may inhibit bacterial growth. S. pneumoniae will also grow on a chocolate agar plate (CAP).
For H. influenzae, a CAP made with heat lysed blood or supplemented with hemin (X factor) and nicotinamide-adenine-dinucleotide (NAD; V factor) should be used. Growth of H. influenzae on a BAP may be achieved by adding a source of NAD, traditionally done by cross-streaking the inoculated medium with a Staphylococcus aureus or Enterococcus species strain. H. influenzae forms satellite colonies along the length of the staphylococcal or enterococcal growth. Additionally, applying filter paper (or disks) saturated with hemin and NAD to the surface of the BAP after the medium has been inoculated will produce a halo of growth around the strip or disk.
N. meningitidis grows on both BAP and CAP. Because N. meningitidis grows well in a humid atmosphere, if an infection with N. meningitidis is suspected, laboratorians may choose to add a shallow pan of water to the bottom of the incubator or add a dampened paper towel to the candle jar. The moisture source should be changed regularly to prevent contamination with molds.
Ordinarily, both BAP and CAP are used for subculture. If only one type of plate is available, a CAP should be used because it contains the hemin and NAD needed for H. influenzae, whereas a BAP does not.
If primary cultures appear to be contaminated, selective media may improve the isolation of these bacteria from specimens containing a mixed flora of bacteria and/or fungi. For primary isolation of N. meningitidis, a chocolate agar base containing vancomycin, colistin, nystatin, and trimethoprim can be used. For isolation of S. pneumoniae, tryptic soy agar with 5% sheep blood and either gentamicin, neomycin or sulfamethoxazole-trimethoprim (SXT) may be useful. For isolation of H. influenzae, chocolate agar with bacitracin can be used. Other antibiotic formulations are also available.
-
QC of primary culture media
All primary culture media should be tested for QC to ensure that the media will support the proper growth of N. meningitidis, S. pneumoniae, and H. influenzae. One plate from each new lot of media received should be tested using an appropriate, well-characterized reference strain of N. meningitidis, S. pneumoniae, and/or H. influenzae. In addition, all media should be tested periodically (every 3 months) to ensure that it can support the growth of appropriate bacteria. One uninoculated plate from each new lot should also be tested in order to check for contamination of mold or other organisms in the laboratory and/or incubator. QC should be repeated on plates from a lot if they have been exposed to temperatures above 4°C or if there is reason to suspect that the plates have been contaminated since the initial QC was performed.
Procedure for QC of primary culture media
- Inspect the media for any visible microbial contamination, discoloration, drying, deterioration, or other physical defects that may interfere with use.
- Inoculate the media with pure colonies from 18-24 hour growth of a well-characterized reference strain. Streak for isolation and incubate for 18-24 hours at 35-37°C with ~5% CO2 (or in a candle-jar).
- Incubate an uninoculated plate for 18-24 hours at 35-37°C with ~5% CO2 (or in a candle-jar).
- Examine the inoculated and uninoculated plates after 18-24 hours.
Reading QC testing results
- Passing result: proper growth of the reference strain on appropriate media and no growth on uninoculated media.
- Failing result: no growth or poor growth of the reference strain on appropriate media and growth of organisms on the uninoculated media.
-
- Inoculation of primary culture media from CSF specimens
- Primary culture directly from CSF
- If the CSF can be transported to a microbiology laboratory immediately (within 1 hour from the time of collection) for culture and analysis, inoculate 1-5 drops of CSF (depending on volume received in laboratory) directly onto both a BAP and CAP within 1 hour after collection.
- If the CSF was centrifuged, use 1 drop of the well-mixed sediment for primary culture.
- Using a sterile bacteriological loop, cross-streak the inoculum to obtain single, isolated colonies.
- A back-up broth (e.g., brain-heart infusion broth with proper supplements) should be inoculated with some of the sediment pellet.
- Agar plates and broth inoculated with the CSF sediment should be incubated for 18-24 hours at 35-37°C with ~5% CO2 (or in a candle-jar).
- If the CSF can be transported to a microbiology laboratory immediately (within 1 hour from the time of collection) for culture and analysis, inoculate 1-5 drops of CSF (depending on volume received in laboratory) directly onto both a BAP and CAP within 1 hour after collection.
- Primary culture from Trans-Isolate (T-I) medium
- If the CSF cannot be transported to a microbiology laboratory immediately (within 1 hour from the time of collection) for culture and analysis, a bottle of T-I medium should be inoculated (1). To do this remove the aluminum cap with forceps, wipe the rubber stopper with a 70% alcohol swab (do not use povidone-iodine) and use a syringe to aseptically inoculate 0.5-1.0 ml of the CSF into the T-I medium for transport and growth of bacteria.
- If the T-I medium cannot be transported to a microbiology laboratory the same day of inoculation, insert a venting needle (sterile cotton-plugged hypodermic needle) through the rubber stopper of the T-I bottle, which will encourage growth and survival of the bacteria.
- Be sure that the venting needle does not touch the broth.
- Incubate the inoculated T-I medium at 35-37°C with ~5% CO2 (or in a candle-jar) overnight or until transport is possible. If transportation is delayed more the 4 days, remove the vented T-I bottle from the incubator or candle jar and place it at room temperature (25°C) until shipment.
- Remove the venting needle and wipe the rubber stopper with 70% alcohol before shipment. It is essential to avoid contamination when sampling the bottles to obtain specimens aseptically.
- Once the T-I medium arrives in the microbiological laboratory, it can be cultured immediately.
- If the T-I medium cannot be transported to a microbiology laboratory the same day of inoculation, insert a venting needle (sterile cotton-plugged hypodermic needle) through the rubber stopper of the T-I bottle, which will encourage growth and survival of the bacteria.
- If the T-I medium can be transported to a microbiology laboratory the same day of inoculation, do not vent the T-I bottle until it arrives in the receiving laboratory. Upon arrival, wipe the rubber stopper with 70% alcohol, insert a venting needle into the T-I bottle, incubate at 35-37°C with ~5% CO2 (or in a candle-jar), and observe daily for turbidity in the liquid phase for up to 7 days.
- Prior to subculture, remove the venting needle and wipe the rubber stopper with 70% alcohol.
- Do not use povidone-iodine on the rubber stopper as it may be carried into the medium by the passing needle, thus inhibiting the growth of bacteria.
- After 18-24 hours of incubation at 35-37°C with ~5% CO2 (or in a candle-jar) with a venting needle, use a sterile needle and syringe to transfer 50-100 µl of the liquid portion of the T-I medium onto both a BAP and CAP for primary culture.
- Approximately 50-100 µl is used to streak each plate. To streak two plates, draw approximately 100-200 µl with the syringe at one time to minimize the possibility of contaminating the T-I medium.
- Streak the BAP and CAP for isolation, incubate the plates at 35-37°C with ~5% CO2 (or in a candle-jar), and examine the plates daily for up to 72 hours.
- If no growth is observed, subculture the T-I medium again on day 4 and day 7.
- Isolates should always be inspected for purity of growth by looking at colony morphology before any testing is performed. If any contamination is seen, cultures should be re-streaked to ensure purity prior to testing.
- If the T-I medium appears to be contaminated, selective media may be used (see Section II.A.).
- If the CSF cannot be transported to a microbiology laboratory immediately (within 1 hour from the time of collection) for culture and analysis, a bottle of T-I medium should be inoculated (1). To do this remove the aluminum cap with forceps, wipe the rubber stopper with a 70% alcohol swab (do not use povidone-iodine) and use a syringe to aseptically inoculate 0.5-1.0 ml of the CSF into the T-I medium for transport and growth of bacteria.
- Primary culture directly from CSF
-
Processing blood specimens
Laboratory personnel handling blood culture specimens must be able to isolate bacteria on appropriate primary culture media and properly subculture isolates to obtain pure cultures for testing.
-
Primary culture from a blood culture bottle
The blood culture bottle should be immediately inoculated (within 1 minute) after venipuncture to prevent the blood from clotting in the syringe. The inoculated blood culture bottle should be transported to a microbiology laboratory as soon as possible for incubation and subculture.
- If transport to a microbiology laboratory is not possible the same day, place the blood culture bottle in an incubator at 35-37°C with ~5% CO2 (or in a candle-jar) until transport is possible. Inoculated blood culture bottles should not be placed in the refrigerator.
- If transport to a microbiology laboratory is feasible the same day, incubate the blood culture bottle at 35-37°C with ~5% CO2 (or in a candle-jar).
- Examine the blood culture bottle for turbidity at 14-17 hours and then every day for up to 7 days. Any turbidity or lysis of erythrocytes may be indicative of growth, and subcultures onto primary culture media should be made immediately.
- Because N. meningitidis, S. pneumoniae, and H. influenzae are fragile organisms, subcultures should be performed on day 4 and day 7 regardless of turbidity, as the absence of turbidity does not always correlate with the absence of bacterial growth.
- Before subculture, swirl the blood culture bottle several times to mix the contents.
- Disinfect the rubber septum of the blood culture bottle with a 70% alcohol swab.
- Do not use povidone-iodine on the rubber septum as it may be carried into the medium by the passing needle, thus inhibiting the growth of bacteria.
- Alternatively, if the blood culture bottle has a screw-cap, open the bottle and remove the fluid using sterile technique (i.e., flaming the bottle mouth upon opening and closing the cap).
- Aspirate 1 ml with a sterile syringe and needle from the blood culture bottle and transfer 0.5 ml to a BAP and 0.5 ml to a CAP.
- Streak the plates for isolation, incubate at 35-37°C with ~5% CO2 (or in a candle-jar), and examine daily for up to 72 hours.
- Isolates should always be inspected for purity of growth by looking at colony morphology before any testing is performed. If any contamination is seen, cultures should be re-streaked to ensure purity prior to testing.
- Once pure bacterial growth has been confirmed by subculture from the blood culture bottle, the bottle should be disposed of according to proper safety procedures.
-
MacConkey agar media
If the microbiology laboratory has the resources to support the use of a third plate for subculture, MacConkey agar should be used, particularly if the specimen was obtained from a patient with fever of unknown origin, when typhoid fever (S. typhi) is suspected symptomatically, or if a Gram stain of blood culture broth reveals gram-negative bacilli. MacConkey agar is designed to grow gram-negative bacteria and stain them for lactose fermentation, in order to distinguish those that can ferment the sugar lactose (Lac+) from those that cannot (Lac-). It contains bile salts (to inhibit most gram-positive bacteria, except Enterococcus and some species of Staphylococcus, i.e., Staphylococcus aureus), crystal violet dye (which also inhibits certain gram-positive bacteria), neutral red dye, (which stains microbes fermenting lactose), lactose, and peptone.
- Transfer approximately 0.5 ml of the blood culture broth onto MacConkey agar and streak for isolated colonies.
- Incubate the MacConkey agar for 18-24 hours at 35-37°C with ~5% CO2 (or in a candle-jar).
- Inspect plate for growth and identify the bacteria (Figure 9).
-
-
Macroscopic examination of colonies
Presumptive identification of N. meningitidis, S. pneumoniae, and H. influenzae can be made on the basis of growth and colony morphology on a BAP and CAP and a Gram stain of the organisms (Table 1 and Figures 10 and 11).
Table 1. Presumptive identification of N. meningitidis, S. pneumoniae, and H. influenzae based on growth on primary culture media and Gram stain results
Growth on CAP Growth on BAP Gram stain Presumptive ID + + gram-negative diplococci N. meningitidis + + gram-positive diplococci S. pneumoniae + - gram-negative pleomorphic H. influenzae H. influenzae appear as large, colorless-to-grey, opaque colonies on a CAP (Figure 12). No hemolysis or discoloration of the medium is apparent. Encapsulated strains appear more mucoidal than non-encapsulated strains, which appear as smaller compact grey colonies. H. influenzae cannot grow on a BAP.
Young colonies of N. meningitidis are round, smooth, moist, glistening, and convex, with a clearly defined edge on a BAP (Figure 13). Some colonies appear to coalesce with other nearby colonies. Actively growing colonies of N. meningitidis on a BAP are grey and unpigmented. Older cultures (> 24 hours) become more opaquely grey and sometimes cause the underlying agar to turn dark. On a CAP, N. meningitidis appear similar to H. influenzae (see description above). While H. influenzae produce a pungent indol smell that can differentiate it from N. meningitidis, plates should not be opened in order to smell the cultures.
S. pneumoniae appear as small, grey, moist (sometimes mucoidal), watery colonies with a surrounding green zone of alpha-hemolysis on a BAP (Figure 14) and CAP. The degree of mucoidness of S. pneumoniae colonies is strain and serotype dependent and is also influenced by the freshness of the medium and the incubation atmosphere. Some serotypes appear more mucoidal than others; the fresher the medium, the more mucoidal the cultures appear. Young pneumococcal colonies appear raised, similar to viridans streptococci. Differentiating pneumococci from viridans streptococci on a CAP is difficult. However, once the pneumococcal culture ages 24-48 hours, the colonies become flattened, and the central portion becomes depressed, which does not occur with viridans streptococci (Figure 15). A microscope (30X-50X) or a 3X hand lens can also be a useful tool in differentiating pneumococci from alpha-hemolytic viridans streptococci.
Other organisms that might appear on the culture plate along with S. pneumoniae are Staphylococcus aureus, Staphylococcus epidermidis, or another Staphylococcus species. Figure 16 shows the two different types of colonies growing on a BAP. The dull gray flat colony surrounded by a green zone of hemolysis is S. pneumoniae and the white colony with no hemolytic activity is S. epidermidis.
- Page last reviewed: April 15, 2016
- Page last updated: March 13, 2015
- Content source:


 ShareCompartir
ShareCompartir